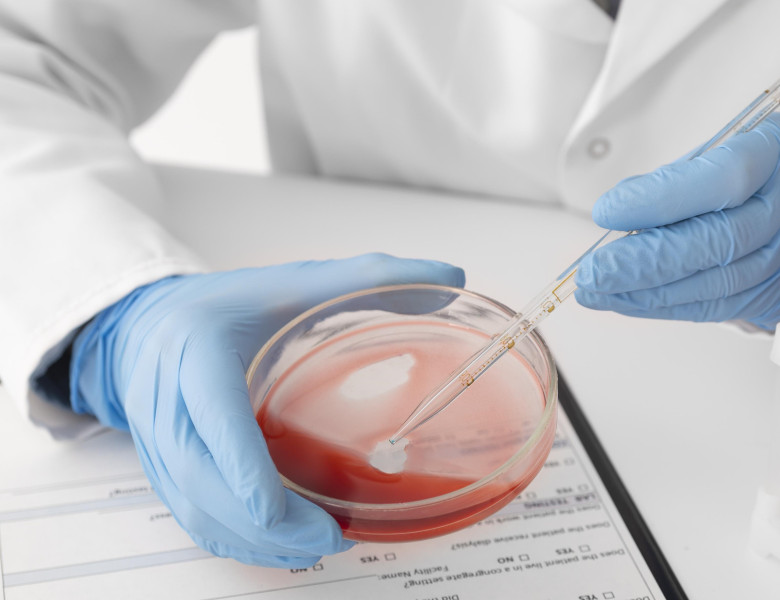
analiza sange

Excesul de fier este mult mai puţin cunoscut decât deficitul de fier, deşi poate avea consecinţe la fel de grave. Hemocromatoza este o afecţiune genetică frecventă, tratabilă, dar care rămâne adesea nediagnosticată, tocmai pentru că simptomele ei sunt nespecifice sau apar târziu, când organele sunt deja afectate.
Hemocromatoza este o boală genetică moştenită (ereditară) care influenţează cantitatea de fier absorbită din alimente. Afecţiunea este mai frecventă la persoanele de origine irlandeză, scoţiană sau galeză, motiv pentru care a fost supranumită „blestemul celtic”. Această denumire poate fi însă înşelătoare, deoarece boala este întâlnită şi în alte populaţii din nordul Europei, fapt care contribuie la subdiagnosticarea ei.
În hemocromatoză, organismul absoarbe prea mult fier din alimentaţie. Fierul este esenţial pentru sănătate, în special pentru capacitatea globulelor roşii de a transporta oxigenul. La persoanele sănătoase, excesul este depozitat în siguranţă în măduva osoasă şi în ficat, sub formă de feritină. La pacienţii cu hemocromatoză, aceste depozite ajung treptat la niveluri care nu mai sunt considerate sigure, scrie News.ro.
Ce se întâmplă când organismul este supraîncărcat cu fier
Întrucât organismul nu are un mecanism eficient de eliminare a fierului în exces, mineralul se acumulează în ţesuturi şi organe, producând leziuni progresive.
Cele mai multe cazuri sunt cauzate de mutaţii ale genei HFE, care controlează hepcidina, un hormon produs de ficat ce reglează absorbţia fierului. Când acest sistem este afectat, absorbţia continuă necontrolat. De regulă, mutaţia este moştenită de la ambii părinţi. Supraîncărcarea cu fier poate apărea şi în alte situaţii, de exemplu la persoanele care necesită transfuzii repetate de sânge.
Ficatul este deosebit de vulnerabil. Excesul de fier poate provoca inflamaţie, fibroză ireversibilă şi, în stadii avansate, cancer hepatic. După depăşirea capacităţii de stocare a ficatului, fierul se depune şi în alte organe, precum pancreasul, inima, articulaţiile sau creierul, afectând funcţia acestor organe.
Hemocromatoza genetică a fost identificată inclusiv în resturi umane din epoca bronzului şi din populaţii neolitice din Irlanda. Se consideră că mutaţia HFE oferea un avantaj de supravieţuire în condiţiile unor diete sărace în fier.
Deşi incidenţa este mai mare în rândul persoanelor de origine celtică, hemocromatoza poate apărea la orice populaţie, însă continuă să fie percepută în mod eronat ca o afecţiune rară.
Aproximativ una din 200 de persoane de origine nord-europeană este purtătoare a mutaţiilor care pot duce la hemocromatoză. În Irlanda, frecvenţa este şi mai mare, de aproximativ 1 din 83 de persoane. Înainte de identificarea bazei genetice a bolii, diagnosticul era adesea pus întâmplător sau după apariţia cirozei hepatice ori a diabetului.
Simptomele și tratamentul hemocromatozei. Cum se ajunge la diagnostic
În prezent se ştie că simptomele sunt variate şi pot avea intensitate diferită. Cea mai frecventă manifestare este durerea articulară, în special la nivelul articulaţiilor mâinilor. Alte simptome includ oboseala cronică, colorarea brună a pielii, scăderea libidoului, tulburările de ritm cardiac şi dificultăţile de memorie sau concentrare.
Mulţi pacienţi nu au simptome evidente timp de zeci de ani, iar atunci când apar, acestea sunt adesea puse pe seama înaintării în vârstă sau a altor afecţiuni frecvente.
Studii de amploare pe populaţia din Marea Britanie arată că până la 40% dintre persoanele cu hemocromatoză genetică dezvoltă cel puţin un simptom legat de supraîncărcarea cu fier de-a lungul vieţii. Bărbaţii prezintă cel mai mare risc de cancer hepatic. Cu toate acestea, numeroşi pacienţi rămân nediagnosticaţi chiar şi după apariţia unor leziuni severe de organ.
Potrivit organizaţiei Haemochromatosis UK, cazurile nediagnosticate generează costuri anuale de sute de milioane de euro pentru sistemul de sănătate britanic, prin complicaţii care ar putea fi prevenite.
Diagnosticul este relativ simplu. Analizele de sânge pot evidenţia nivelurile de fier şi funcţia hepatică. Dacă rezultatele sugerează supraîncărcare cu fier, testarea genetică poate confirma boala. Dificultatea constă în identificarea persoanelor care ar trebui testate, deoarece simptomele sunt nespecifice, iar afecţiunea este adesea ignorată.
Tratamentul este eficient şi constă, în principal, în recoltări regulate de sânge, procedură numită flebotomie. Prin eliminarea sângelui, organismul este forţat să utilizeze fierul depozitat pentru a produce noi celule sanguine. Iniţial, procedura poate fi efectuată săptămânal sau la două săptămâni, până la normalizarea nivelurilor de fier, urmată de monitorizare pe termen lung.
Ajustările alimentaţiei pot reduce ritmul acumulării fierului, însă nu pot substitui tratamentul prin flebotomie. La pacienţii care nu tolerează recoltările regulate, pot fi utilizate medicamente chelatoare de fier, care favorizează eliminarea acestuia prin urină, deşi efectele adverse limitează utilizarea lor. În prezent sunt evaluate şi terapii noi, inclusiv medicamente care imită hepcidina sau care blochează transportul fierului.
Hemocromatoza este o boală frecventă şi tratabilă. Atunci când este depistată precoce, efectele asupra sănătăţii pot fi prevenite în mare măsură. Principala provocare rămâne creşterea nivelului de conştientizare, atât în rândul medicilor, cât şi al populaţiei generale, pentru ca diagnosticul să fie stabilit înainte de apariţia leziunilor ireversibile.
Citește și: Riscul de Alzheimer, redus cu aproape 40% printr-un obicei simplu practicat toată viața
- Te-ar putea interesa si:
- Ce se întâmplă cu tensiunea ta arterială când mănânci banane. Explicațiile cardiologilor
- Ce efecte negative pot avea îndulcitorii din băuturile dietetice. Nu sunt neapărat o alternativă...
- Un medicament ar putea elimina necesitatea transplantului hepatic în afecţiuni ale căilor biliare